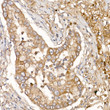
Immunohistochemistry analysis of paraffin-embedded Human lung cancer using NUMB Rabbit pAb (STJ111671) at dilution of 1:100 (40x lens). High pressure antigen retrieval performed with 0. 01M Citrate Bufferr (pH 6. 0) prior to immunohistochemistry staining.

Anti-NUMB antibody (521-640) (STJ111671)
SPECIFICATIONS
ClonalityPolyclonal
HostRabbit
ConjugationUnconjugated
IsotypeIgG
General Information
| Short Description | Rabbit polyclonal NUMB (521-640) antibody for use in WB, IHC-P, IF, ICC and ELISA in human, mouse and rat samples. Datasheet included with dilution recommendations, and related reagents. |
| Applications | WB/IHC-P/IF/ICC/ELISA |
| Host | Rabbit |
| Reactivity | Human/Mouse/Rat |
| Note | STRICTLY FOR FURTHER SCIENTIFIC RESEARCH USE ONLY (RUO). MUST NOT TO BE USED IN DIAGNOSTIC OR THERAPEUTIC APPLICATIONS. |
Product Properties
| Clonality | Polyclonal |
| Isotype | IgG |
| Conjugation | Unconjugated |
| Concentration | Lot specific |
| Purification | Affinity purification |
| Dilution Range | WB:1:500-1:1000IHC-P:1:50-1:200IF/ICC:1:50-1:200ELISA:Recommended starting concentration is 1 Mu g/mL. Please optimize the concentration based on your specific assay requirements. |
| Formulation | PBS with 0.05% Proclin300, 50% Glycerol, pH 7.3. |
| Storage Instruction | Store at-20°C for up to 1 year from the date of receipt, and avoid repeat freeze-thaw cycles. |
Target Information
| Gene Symbol | NUMB |
| Gene ID | 8650 |
| Uniprot ID | NUMB_HUMAN |
| Immunogen Region | 521-640 |
| Immunogen Sequence | SQMVANVFGTAGHPQAAHPH QSPSLVRQQTFPHYEASSAT TSPFFKPPAQHLNGSAAFNG VDDGRLASADRHTEVPTGTC PVDPFEAQWAALENKSKQRT NPSPTNPFSSDLQKTFEIEL |
| Specificity | Recombinant fusion protein containing a sequence corresponding to amino acids 521-640 of human NUMB (NP_003735.3). |
Additional Info
| Post Translational Modifications | Phosphorylated on Ser-276 and Ser-295 by CaMK1. Isoform 1 and isoform 2 are ubiquitinated by LNX leading to their subsequent proteasomal degradation. Ubiquitinated.mediated by SIAH1 and leading to its subsequent proteasomal degradation. |
| Function | Regulates clathrin-mediated receptor endocytosis. Plays a role in the process of neurogenesis. Required throughout embryonic neurogenesis to maintain neural progenitor cells, also called radial glial cells (RGCs), by allowing their daughter cells to choose progenitor over neuronal cell fate. Not required for the proliferation of neural progenitor cells before the onset of neurogenesis. Also involved postnatally in the subventricular zone (SVZ) neurogenesis by regulating SVZ neuroblasts survival and ependymal wall integrity. May also mediate local repair of brain ventricular wall damage. |
| Protein Name | Protein Numb HomologH-NumbProtein S171 |
| Database Links | Reactome: R-HSA-2122948Reactome: R-HSA-437239Reactome: R-HSA-5610780Reactome: R-HSA-5632684Reactome: R-HSA-9725554 |
| Cellular Localisation | Cell MembranePeripheral Membrane ProteinCytoplasmic SideEndosome MembraneLocalizes To Perinuclear Endosomes In An Aak1-Dependent Manner |
| Alternative Antibody Names | Anti-Protein Numb Homolog antibodyAnti-H-Numb antibodyAnti-Protein S171 antibodyAnti-NUMB antibodyAnti-C14orf41 antibody |
Information sourced from Uniprot.org